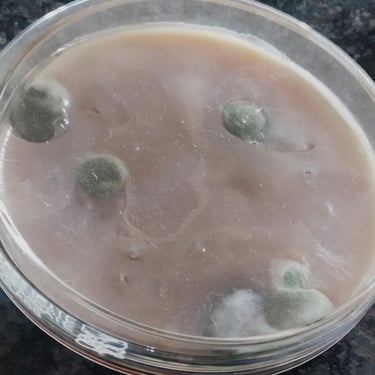

WHY do children forget answers before exams, but remember cycling forever?
Anything learned through demonstration, experiments, and practice has a lasting impact on our memory. The hands-on experience and active engagement involved in these methods make the knowledge more memorable and effective. When we see something in action or actively participate in an experiment, our brain forms connections and associations that help us retain the information for a long time. On the other hand, things learned through traditional teaching methods, such as a lecture or chalk-and-talk, tend to be easily forgotten. Simply listening to someone speak or reading from a textbook may not engage our minds as much, making it harder to retain the information. Therefore, it is essential to incorporate interactive and experiential learning techniques to ensure better knowledge retention and understanding.
All Labs, No Lectures
Teaching by Demonstrations and Mastering by Experiments (TDLE) Using Advanced Vernier Sensors and Technology
Concept labs are innovative classrooms designed to teach concepts through practical demonstrations and experiments. At our school, we are proud to offer approximately 1,000 experimental apparatus designed to foster foundational understanding in various subjects, including physics, chemistry, biology, computer science, and mathematics. These hands-on tools are integral to the learning process, enabling students from primary classes to engage with complex concepts in a tangible way. By experimenting with these resources, students not only grasp theoretical knowledge but also develop critical thinking and problem-solving skills. Our commitment to experiential learning ensures that students can explore, hypothesize, and discover, laying a strong groundwork for their future academic endeavors. The rich array of apparatus supports a dynamic and interactive learning environment, making science and mathematics accessible and enjoyable for all.



































Hundreds of Apparatus (Including from Vernier - USA)
for development of Concepts

Concept Labs : Demonstrations & Experiments for Concept Building
Student Learns through demonstrations & experiments rather than Chalk-and-talk
Easy, fast, life-long and each and every student develop concepts




Concept Labs : demonstrations & Experiment from regular classess
Student Learns through demonstrations & experiments rather than Chalk-and-talk
Easy, fast, life-long and each and every student develop concepts




CONCEPTS LABS: Build your own dreams
Student Learns through demonstrations & experiments rather than Chalk-and-talk
Easy, fast, life-long and each and every student develop concepts




Our office
Near DurgaShakti Foods Pvt. Ltd.
Sajanpuri, Khamgaon, M. S. 444303
Contacts
thecreator.school@gmail.com
9172221415 /16/18

Cultivating Global Problem-Solvers
